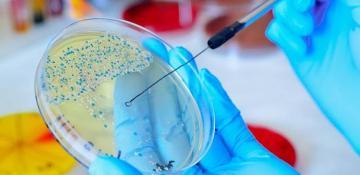
Scientists urge halt on ‘mirror life’ microbe research due to potential risks

- News
- Antibiotics
Tag:
Antibiotics
-
A group of world-leading scientists, including Nobel laureates, has called for an immediate halt to research on creating "mirror life" microbes, citing concerns about the potential dangers these synthetic organisms pose to life on Earth.13 Dec 2024-14:58
-
-